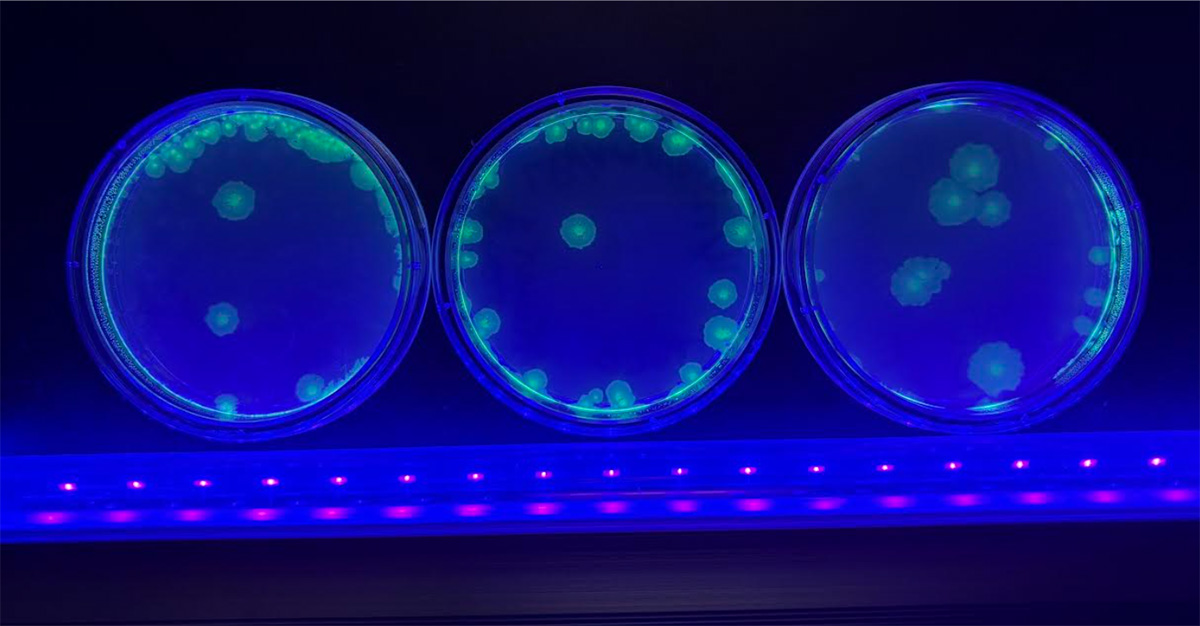

Hello! My name is Luz Rojas, I am a senior at Fresno High School, and this is my second year enrolled as a student at The Center for Advanced Research and Technology (CART). I am currently enrolled in the Biotechnology Lab, but was previously enrolled in the Environmental Science lab where we researched the conditions of the San Joaquin River for the reintroduction of Chinook Salmon during the Fall semester, and in the spring, dived into the importance of irrigation water management with the help and guidance of an environmental professional. Both labs have not only enriched my learning through hands-on experiences, but have given me the experience of certified researchers.
Taking a look into the Biotechnology lab, students have been preparing for their Winter Showcase that takes place the first week of second semester. Each group of students is presenting a specific biotechnology solution that aims to solve a societal problem. Aside from preparing for this big presentation, students have also been modifying E.coli DNA to make it glow!! This process was done by introducing a pGLO plasmid into the bacteria. Under Ultra Violet lights, students were able to assess whether or not the DNA of the E.coli bacteria was successfully modified.
Taking a look into the English portion of the Biotechnology Lab, students began reading The Andromeda Strain by Micheal Crichton. This novel dives into the deadly outbreak of an extraterrestrial microorganism that whipped out the entire population of Arizona and the investigation done by the Wildfire team, a group of scientists investigating the bacteria. Adding on, students are also writing a research report on a pandemic/epidemic of their choice. As deadlines are approaching, students continue to do individual research, and are eager to receive constructive feedback that will help them improve and further their knowledge on writing research papers.
Overall, CART is an amazing opportunity for students who are interested in exploring different career fields. At CART, students are given the hands-on and real life experience of what it is to work in the career fields that are offered. As a second year student, I have seen significant growth in my presenting skills, and writing skills. I have also noticed growth as a teammate and have learned to work in groups. Not only have I gained new educational experiences, but I have also gained life long friends that have similar interests as me. I highly recommend students to enroll into CART if they are looking for a fun and engaging learning experience that will help them solidify their future career and goals! :)